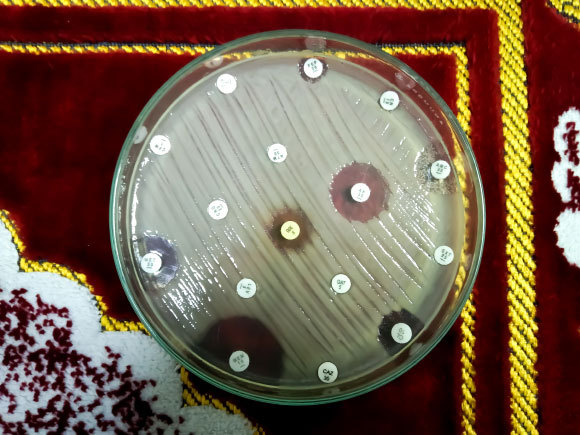
**תמונה של צלחת פטרי** אחד האיומים הגדולים ביותר שעומדים בפני האנושות הוא ההתפתחות של חיידקים שעמידים לסוגים רבים של אנטיביוטיקה. | צילום: Arif biswas Shutterstock

האם חיידקים משמיעים צלילים? האם אפשר לשמוע אותם? אילו יכולנו להקשיב לחיידקים, כמו שמקשיבים לפעימות הלב, הייתה לנו דרך יעילה לדעת אם הם חיים או מתים. כעת, במחקר שפורסם בכתב העת Nature Nanotechnology, הצליח צוות מדענים להקליט את פסקול חייהם של חיידקים המתועד על תופים זעירים העשויים גרפן.
חיידקים הם יצורים קטנים מאוד, שקשה מאוד לעקוב אחרי תנועתם. קבוצת חוקרים מהולנד הצליחה לפתח תוף מיקרוסקופי רגיש במיוחד שבעזרתו אפשר לשמוע את תנועת החיידקים ולהקליט את קולות הנגינה שלהם עליו. לשם כך הם לקחו שכבה של גרפן – חומר חזק ודק במיוחד העשוי שכבה אחת של אטומי פחמן המסודרים במבנה סריגי, מתחו אותה מעל חלל ויצרו מבנה שנראה כמו עור תוף היושב על תיבת תהודה.
אבל האם החיידק אכן ינגן בתוף שהם בנו? החוקרים רצו שהתוף יהיה רגיש אפילו לחיידק בודד. הם הניחו עליו חיידק אי קולי (Escherichia coli), וראו שהוא אכן נצמד לפני השטח של תוף הגרפן ומניע אותו מעלה ומטה. מדובר בתנועה זעירה של 20 ננומטר בממוצע, כלומר 20 מיליארדיות המטר, והיא יכולה להגיע עד 60 ננומטר לכל היותר. זה בערך פי 4,000 פחות מעובי של שערה דקה.
את התנודות שנוצרו בתוף הם מדדו בעזרת לייזר והמירו את המקצבים הננומטרים לצליל של רעש עולה ויורד, הדומה במקצת לאוושת הרוח או להמיית גלי ים. את הנגינה הזאת אפשר לפרש כאיתות מצד החיידק על כך שהוא חי ומתפקד. אומנם המוזיקה פחות נעימה מסונטה של מוצרט או סימפוניה של בטהובן, אבל לראשונה הצליחו לשמוע את תנועת החיידקים.

החוקרים ראו שהחיידק נצמד לפני השטח של ה"תוף" ומניע אותו מעלה ומטה. | אילוסטרציה: Irek Roslon – TU Delft
צלילי המוזיקה
התנודות שיוצרות את הצלילים בתופי הגרפן נובעות בעיקר מתנועת השוטונים של החיידקים – מעין זנבות שמאפשרים להם לשחות בנוזל.
כדי להראות את זה השתמשו החוקרים בכמה זנים של חיידקי אי. קולי מהונדסים הנבדלים זה מזה במספר השוטונים או ברמת הפעילות שלהם. למשל זן תנועתי במיוחד בעל כמה שוטונים, זן מוגבל תנועה שפעילות השוטונים שלו פגומה או זן חסר שוטונים שאינו נע בכלל. הם ראו שהשוטונים פועלים כמו מקלות לתופים. ככל שהם פעילים יותר, כך גוברות גם תנודות התוף. אף על פי שתנועת השוטונים היא הגורם העיקרי לנגינת החיידקים, גם חיידקים חסרי שוטונים הניעו את יריעת הגרפן, אך הרבה יותר חלש וכנראה באמצעות מנגנון אחר.
דממת מוות
צלילי החיידק יכולים לשמש "רעש לבן" או כצלילי רקע מרגיעים. אך האם אפשר להשתמש בשיטה למטרות רפואיות?
אחד האיומים הגדולים ביותר שעומדים בפני האנושות הוא ההתפתחות של חיידקים שעמידים לסוגים רבים של אנטיביוטיקה, תכונה שמקשה מאוד לטפל בחולים שנדבקו בהם. היקף הבעיה גדול מאוד ובכל שנה מתים יותר מ-1.2 מיליון איש ברחבי העולם מחיידקים עמידים. ארגון הבריאות העולמי התריע כי מדובר בבעיה דחופה שמחייבת שיתוף פעולה עולמי בבלימתה ותוכנית מחייבת למעבר לשימוש מושכל יותר בתרופות האנטיביוטיות הקיימות, שיפור אמצעי האבחון ופיתוח תרופות חדשות.
אחד האיומים הגדולים ביותר שעומדים בפני האנושות הוא ההתפתחות של חיידקים שעמידים לסוגים רבים של אנטיביוטיקה. | צילום: Arif biswas Shutterstock
אחת הדרכים להפחית את הסכנה להתפתחותם של חיידקים עמידים היא להקפיד לא לרשום לחולים אנטיביוטיקה שלא לצורך, כשמחלתם אינה נובעת מזיהום חיידקי. כמו כן רצוי להתאים מלכתחילה לכל חולה אנטיביוטיקה מתאימה, שהחיידק שפגע בו רגיש אליה.
כשרוצים כיום לבדוק אם חיידק עמיד לאנטיביוטיקה מסוימת, אין ברירה אלא להשתמש בשיטה איטית למדי, שדורשת כמה ימים לקבלת תשובה. בזמן הזה מבודדים את החיידק מרקמות החולה ומגדלים אותו במעבדה עד שמתקבלת כמות מספיק גדולה של חיידקים. לתרבית הזאת מוסיפים את האנטיביוטיקה ובוחנים אם היא מצליחה להרוג את החיידקים או לעכב ביעילות את התרבותם. מכיוון שהתהליך כל כך ממושך, נהוג להתחיל לטפל בחולה באנטיביוטיקה רחבת טווח עוד לפני קבלת התוצאות. לעיתים מתברר בדיעבד שהטיפול הזה אינו מתאים, אינו יעיל ואולי אף מיותר.
תוף הגרפן עשוי לזרז מאוד את האבחון. כשנתנו אנטיביוטיקה לחיידק שהונח על תוף כזה, זמן הבדיקה התקצר מימים לשעות. אם החיידק היה רגיש לתרופה, רעידות התוף דעכו בהדרגה, עד שפסקו לגמרי בתוך שעה עד שעתיים והנגינה חדלה. לעומת זאת, חיידק שהיה עמיד לאנטיביוטיקה הנבדקת המשיך לתופף באין מפריע. בניסוי בדקו כמה סוגים נפוצים של אנטיביוטיקה, המבוססים על מנגנוני פעולה שונים, וקיבלו בכולם תשובות אמינות ומהירות.
המהירות הזאת עשויה להיות קריטית, במיוחד כשמדובר בזיהומים מסכני חיים, שבהם כל עיכוב במתן הטיפול המתאים עלול להסתיים במותו של המטופל. היא עשויה לסייע גם מול חיידקים מחוללי מחלה שמתרבים בקצב איטי במיוחד, כמו חיידקי השחפת, שזיהוי העמידות שלהם עלול לארוך זמן רב מאוד. רק לאחרונה דווח כי במקביל למגפת הקורונה עלה מספר המתים מחיידקי השחפת, שרבים מהם עמידים לכל סוגי האנטיביוטיקה הנפוצים, דבר שמדגיש את החשיבות של פיתוח טכניקות מהירות.
שיטה המשמשת לבדיקת רגישות חיידקים לאנטיביוטיקה:
"אנו שואפים לייעל את השיטה המשמשת לבדיקת רגישות חיידקים לאנטיביוטיקה ולאמת אותה מול מגוון דגימות, כך שבסופו של דבר היא תוכל לשמש ערכת כלים אבחנתית יעילה לזיהוי מהיר של עמידות לאנטיביוטיקה", סיכמו החוקרים.
תופי הגרפן מציגים כלי אבחוני מבטיח, אך יש לזכור שמדובר במערכת ניסיונית בלבד. עדיין יש לבדוק את אמינותה עם זני חיידקים נוספים ועם חיידקים חסרי שוטונים ולבחון עד כמה היא יעילה במצבים קליניים אמיתיים, כשהחיידקים נלקחים מחולים אמיתיים. תרביות כאלה עלולות לכלול למשל כמה סוגי חיידקים ביחד, כך שיצטרכו למצוא דרך לבודד את החיידק מחולל המחלה לפני הבדיקה.
הצלחה בהמשך פיתוח השיטה תאפשר לרופאים לבחור תוך זמן קצר בטיפול המתאים והיעיל ביותר לחולה. עד שהשיטה תפותח ותגיע למרפאות אנו יכולים ליהנות מנגינתם של החיידקים.